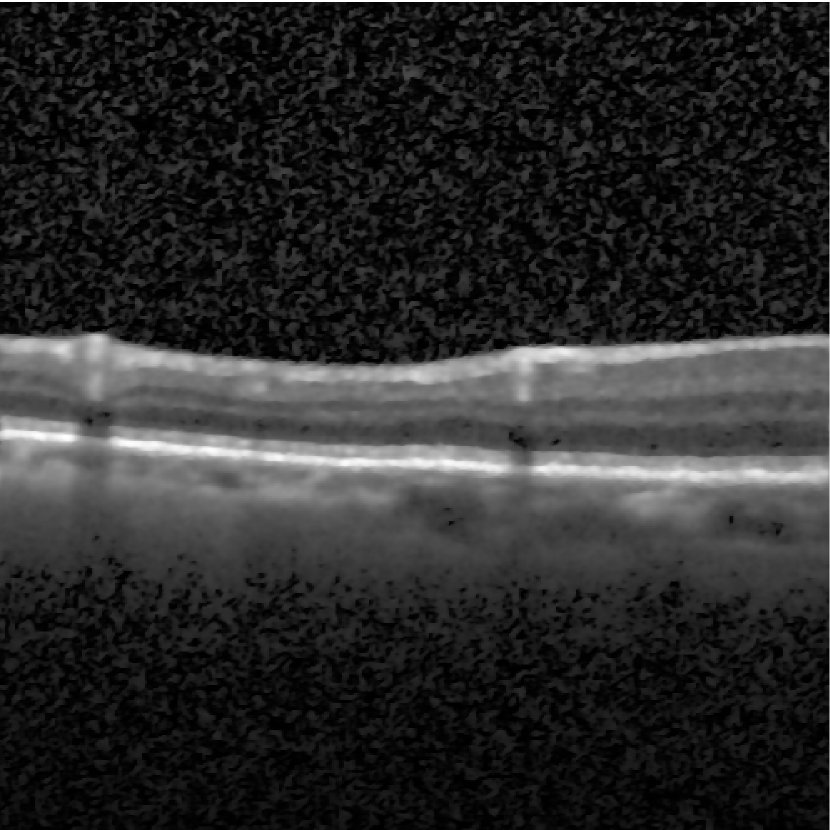
Refer to caption

A Fast Minimization Algorithm for the Euler Elastica ModelZhifang Liu, Baochen Sun, Xue-Cheng Tai, Qi Wang, and Huibin Chang
A Fast Minimization Algorithm for the Euler Elastica Model Based on a Bilinear Decomposition ††thanks: \fundingThe work of the first and last authors is partially supported by the NSFC grants (Nos. 12271404, 11871372, 11501413, and 12301545) and PHD Program 52XB2013 of Tianjin Normal University. The work of Xue-Cheng Tai is partially supported by NSFC/RGC grant N-HKBU214-19 and NORCE Kompetanseoppbygging program.
Abstract
The Euler Elastica (EE) model with surface curvature can generate artifact-free results compared with the traditional total variation regularization model in image processing. However, strong nonlinearity and singularity due to the curvature term in the EE model pose a great challenge for one to design fast and stable algorithms for the EE model. In this paper, we propose a new, fast, hybrid alternating minimization (HALM) algorithm for the EE model based on a bilinear decomposition of the gradient of the underlying image and prove the global convergence of the minimizing sequence generated by the algorithm under mild conditions. The HALM algorithm comprises three sub-minimization problems and each is either solved in the closed form or approximated by fast solvers making the new algorithm highly accurate and efficient. We also discuss the extension of the HALM strategy to deal with general curvature-based variational models, especially with a Lipschitz smooth functional of the curvature. A host of numerical experiments are conducted to show that the new algorithm produces good results with much-improved efficiency compared to other state-of-the-art algorithms for the EE model. As one of the benchmarks, we show that the average running time of the HALM algorithm is at most one-quarter of that of the fast operator-splitting-based Deng-Glowinski-Tai algorithm.
keywords:
Euler Elastica; Hybrid alternating minimization algorithm; Regularization; Bilinear decomposition of the gradient; Curvature-based variational models46N10; 47N10; 65K10; 68U10
1 Introduction
We consider solving the Euler Elastica (EE) model numerically for image defined in , , i.e.,
| (1) |
where and are two positive parameters, and is a given noisy image. The first term, known as the EE energy [18, 17, 6], regularizes the lengths and curvatures of the level curves in the image and thus warrants strong continuity of the edges of underlying image . The second term denotes the fidelity term that measures the difference between given noisy image and its denoised approximation . Such a model has been used for image restoration tasks [23, 4, 7]. However, the energy functional in (1) has a strongly nonlinear term as well as a singularity at places where the gradient vanishes. This poses a great challenge for one to optimize it.
Traditionally, algorithms for the EE model have been designed directly based on the gradient flow method [6, 28, 22]. The Chan-Kang-Shen (CKS) method [6] used a gradient descent scheme for the fourth-order nonlinear Euler-Lagrange equation of the EE model. In order to meet the Courant-Friedrichs-Lewy condition, a small step size needs to be chosen, leading to slow convergence of the CKS method. An accelerated version of the CSK method was proposed by Yashtini and Kang [28] via the Nesterov’s technique [19]. Ringhølm, Lazić, and Schönlieb introduced the discrete gradient scheme to the gradient flow of the smooth variant of the EE model based on the Itoh–Abe discrete gradient scheme [22]. Wang et al. [25] proposed efficient scalar auxiliary variable algorithms for more general curvature minimization problems. In order to deal with nonconvexity of (1), convex approximations [4] or relaxation methods [5] were used to reformulate the EE energy in higher dimensional spaces. Bredies, Pock, and Wirth in [4] proposed a convex, lower semi-continuous, coercive approximation of the EE energy by functional lifting of the image gradient, and showed some promising results using a tailored discretization of measures. In the work by Chambolle and Pock [5], the EE energy was represented through a convex functional defined on divergence-free vector fields, and successfully applied to diverse shape and image processing tasks utilizing a staggered grid discretization baseed on an averaged Raviart-Thomas finite element approximation.
The variable splitting method was developed to address issues of strong nonlinearity, nonsmoothness, and singularity of (1) in [23, 8, 34, 30, 28, 7, 16, 15, 11, 32]. By introducing auxiliary variables, Tai, Hahn, and Chung in [23] proposed a sophisticated relaxation of the EE model and reformulated the energy minimization problem into an equivalent constrained optimization problem, which was then solved by an augmented Lagrangian method [9, 27]. Inspired by this work, there have been extensive studies of variable splitting and augmented Lagrangian method for the EE model. Duan, Wang, and Hahn [8] introduced one more auxiliary variable for the mean curvature and presented a new augmented Lagrangian method. Zhang and Chen in [29] proposed an augmented Lagrangian primal-dual algorithm for the EE model. Yashtini and Kang in [28] relaxed the normal vector in the curvature term of the EE model and developed the relaxed normal two-split (RN2Split) method. Zhang et al. in [30] and Liu et al. in [16] improved the classical augmented Lagrangian method for the EE model via a linearization technique and the proximal method, respectively. Recently, based on the Lie scheme, Deng, Glowinski, and Tai [7] proposed a stable and fast operator-splitting algorithm dubbed the DGT algorithm. Liu and his collaborators extended the DGT algorithm to a color EE model [14] and the Gaussian curvature regularization model [13]. He, Wang, and Chen in [11], adopted a smoothed constrained relaxation model of (1) and proposed a convergent penalty relaxation algorithm (dubbed the HWC algorithm) for the discrete EE model.
Although most variable-splitting methods can solve the EE model efficiently, their theoretical convergence is difficult to prove due to the complex relations among the coupled auxiliary variables. Especially in [7], the objective functionals based on the Marchuk–Yanenko scheme [10] for the DGT algorithm are nonsmooth and nonconvex such that it is still unclear how to prove the local convergence to the stationary points of the EE model. Numerical oscillations observed from the relative error (See Figures 4, 5 in [7]) may affect the convergence speed. By introducing an additional auxiliary variable for the Hessian matrix, an operator-splitting algorithm was developed for a more complicated Gaussian-curvature regularized model recently [13], which was also based on the Marchuk–Yanenko scheme. However, a rigorous proof of convergence is still elusive and some numerical oscillations remain. We note that the HWC algorithm guarantees convergence but could inflict a high computational cost. It used the lagged diffusivity fixed point iteration and the scheme for the subproblems has to update the coefficient matrices per inner loop.
This paper proposes a new convergent variable-splitting algorithm for the EE model (1) based on a simple yet powerful regularizing, bilinear decomposition. Notice that gradient of the underlying image can be expressed as follows
Denoting and , the gradient is equivalent to the following bilinear decomposition
with two additional constraints. Using the decomposition, the original EE model can be reformulated as a smooth optimization problem with a non-negative and a unit-length constraint. Namely, the EE energy is expressed by a smooth functional of normal vector and magnitude . The singularity in the energy disappears and the strong nonlinearity is also mitigated through the bilinear decomposition. When applying it to image denoising, we further simplify the problem by penalizing the bilinear relation, i.e. adding term to the energy with a large instead of imposing the bilinear decomposition through exact penalization or saddle-point problem traditionally used in constrained optimization. This simplification with a fixed significantly reduces the computational cost.
The reformulation of the EE energy based on a bilinear decomposition of the gradient, relaxation in the constraints through penalties, and the variable splitting technique effectively eliminates the singularity, mitigates the nonlinearity in the original EE model, and improves the regularity of the reformulated energy (objective functional). We then use the finite difference method to discretize the EE energy in space to arrive at a reformulated, discretized EE model. We develop the fast, steadily convergent, hybrid alternating minimization algorithm (HALM) for the discrete EE model. Each subproblem in the new optimization algorithm is solved either in a closed form or approximated efficiently by fast solvers. Under mild conditions, the algorithm is shown to produce a globally convergent minimizing sequence. We discuss the same strategy extended to a list of general curvature-based models, where the corresponding convergence is guaranteed with an Lipschitz smooth curvature term.
Finally, we conduct a host of experiments to show the effectiveness of the algorithms for image denoising. Compared to the other state-of-the-art algorithms, including the DGT and HWC algorithms, the new algorithm converges much faster for both the EE model and general curvature-based model. In benchmark examples, we show that this algorithm requires only one-quarter of the running time to reach the same given tolerance compared to the other fast operator-splitting-based DGT algorithms. In addition, the algorithm is easy to implement numerically since no staggered grid discretization is needed, and only two algorithmic parameters need to be tuned. This essentially three-step algorithm of low computational complexity and costs has a great potential to be applied to other curvature-based models.
The rest of the paper is organized as follows. Section 2 presents the reformulated model and its discretization. Section 3 provides the proposed algorithm for the reformulated discrete model with a rigorous convergence proof. It is extended to the generalized curvature-based model in section 4. Numerical experiments are conducted in section 5 to validate the proposed algorithm and compare the HALM algorithm with the other state-of-the-art ones. Finally, we give conclusions and discuss our future work in section 6.
2 Model reformulation and discretization
In this section, we reformulate the EE model (1) with a bilinear decomposition and then present its discrete form.
2.1 Reformulation of the EE model
A typical difficulty in dealing with the energy in (1) is its weak singularity, i.e. the normal field makes no sense at and may cause numerical instability when the denominator is small. By introducing auxiliary variable , one can express the gradient by the bilinear decomposition:
| (2) |
and reformulate EE model (1) into the following equivalent minimization problem
| (3) | ||||
One may notice that not only does the singularity of the objective functional disappears, but the strong nonlinearity is also mitigated.
We remark that one can extend the bilinear decomposition technique to general curvature-based objective functional [33]
| (4) |
with function (Specific forms will be given in section 4). Based on the bilinear decomposition given in (2), one immediately turns the above minimization problem into an equivalent one as follows:
| (5) | ||||
2.2 Discretization and penalty relaxation
We consider a meshed rectangle domain: with mesh sizes and . The corresponding discrete image domain is defined by
We represent image as a matrix with entries defined in . For convenience, we rearrange this matrix into a vector by the lexicographical column ordering. Given and , belonging to , we denote . Analogously, vectors and are defined.
We introduce two matrices and as follows
and four matrices , , and :
where is the identity matrix, and the symbol denotes the Kronecker product of two matrices. Readily, one can see that
| (6) |
Assuming the periodic boundary condition for , we have
Gradient and divergence are discretized as follows
Remark 2.1.
In variational image processing, the periodic boundary condition is commonly used for historical reasons as well as its benefits in enabling the use of fast discrete Fourier transforms to efficiently solve the linear systems associated with the -subproblem as in the DGT and HWC algorithms. The Neumann boundary condition could also be a natural choice for boundary conditions. With Neumann boundary conditions, the -subproblem can be solved via efficient methods like conjugate gradient (CG) descent and sparse Cholesky factorization. In this work, we will primarily use the periodic boundary condition by default. However, we will also explain how to handle Neumann boundary conditions where appropriate.
Denote the th row of the matrix (or ) as (or ). Using the notations above, we obtain the discrete form of (3):
| (7) | ||||
where represents a vector whose elements are all ones, and represents the standard norm, denotes component-wise product, and denotes the non-negativity of each element. There exists a large family of efficient first-order operator-splitting algorithms [10] to solve discrete model (7) with the bilinear constraint.
Instead of strictly enforcing the constraints, we penalize the bilinear constraint in the objective functional and optimize the augmented objective functional using the alternating minimization method. Specifically, we approximate the constrained minimization problem in (7) by an unconstrained optimization problem given below
| (8) |
where
| (9) | ||||
is a positive parameter, , and the indicator function is defined by
Theorem 1.
Model (9) has at least one minimizer.
The proof of the theorem follows that of theorem 1.4.1 in [21] and is thus omitted. We remark that penalized or relaxation model (9) is equivalent to the original model (7) only when [20]. In practical use, model (9) with a sufficiently large parameter could generate reasonable denoising results, which is also validated numerically.
3 Hybrid alternating minimization algorithm and its convergence
In this section, we present an efficient hybrid alternating minimization method for problem (9) and prove the global convergence of the iterative sequence.
We introduce a smooth function
| (10) | ||||
to rewrite the objective function in (9) as
Note that although is nonconvex, it is strongly convex with respect to and , respectively. The projection onto the sphere is well-defined. Next, based on the alternating minimization strategy, we present an iterative algorithm to minimize .
3.1 Hybrid Alternating Minimization Method
We consider solving problem (9) by minimizing objective function (9) with respect to variables , , and alternately. Supposing that we have at the current -iteration, the proposed Hybrid Alternating Minimization method (HALM) for solving the bilinear decomposition-based EE model (9) updates the variables alternatively as follows
where is a positive parameter, is defined in (10), and
Here, we adopt the forward-backward splitting approach to approximately solve the subproblem as
We will see that each subproblem in the HALM algorithm can be efficiently solved numerically or has a closed-form solution.
The -subproblem is a standard unconstrained quadratic optimization problem
| (11) | ||||
The unique minimum solution is given by
| (12) | ||||
One readily sees that the positive definite matrix is block circulant with circulant blocks (BCCB) such that one can efficiently determine the solution using two-dimensional fast discrete Fourier transform (DFT) [24]. We remark that if assuming the Neumann boundary condition for , the resulting matrix is positive definite as well, such that one can efficiently obtain the solution of (12) using efficient methods such as CG and sparse Cholesky factorization.
The -subproblem is solved by the projection onto the sphere . From (10), one obtain
where denotes the diagonal matrix with the th diagonal entry . Similarly, one has
Then denote
where
| (13) | ||||
| (14) | ||||
This may not be on the unit sphere. We can project it onto the unit sphere by solving independent minimization problems:
| (15) |
where
Here, , where and denote th components of and , respectively. Each problem in (15) has a closed-form solution as follows
| (16) |
where represents the projection operator and is an arbitrary unit vector in .
The -subproblem is also separable. For all , let
Then, -subproblem is described as
where the last equation is derived based on the unit length of . It is 1-dimensional quadratic programming with a nonnegative constraint, and therefore one can directly derive its closed-form solution as follows
| (17) |
In the following section, we will prove the convergence of the HALM algorithm when stepsize is sufficiently small (say, satisfying (22)). For practical use, stepsize is fixed to a constant heuristically.
3.2 Convergence analysis of HALM
We begin with some useful lemmas.
Lemma 3.1 (Lemma 3.3 in [31]).
Let , where the function is convex and the matrix is -independent. Suppose is a stationary point of , i.e. , where is the subdifferential set of the function at , then we have
Lemma 3.2 (Lemma 2 in [3]).
Consider a composite optimization problem
where is a continuously differentiable function with gradient assumed -Lipschitz continuous, is a proper and lower semicontinuous (maybe nonsmooth and nonconvex) function with . Let be a sequence generated by
| (18) | ||||
Then one has
| (19) |
We estimate the Lipschitz constants of the partial derivatives of for the subproblems with respect to single variable , , and , denoted by , , and , respectively. For simplicity, we omit the superscripts and subscripts in the following. The partial derivatives are calculated as follows
| (20) | ||||
where denotes the pointwise module operation. From the first two equations in (20), we obtain the Lipschitz constants of and (with respect to the variables and ) as
| (21) |
and
where denotes the largest eigenvalue of the matrix , and denotes the norm in the Euclidean space.
With regard to and , we consider the compound gradient using the last two equations in (20)
With (the non-negativity condition), the matrix is positive semidefinite, such that one has
Next, we show that the iterative sequence generated by the proposed HALM algorithm has monotonically decreasing objective values.
Lemma 3.3.
Let the sequence be generated by the HALM algorithm with variable stepsize . If
| (22) |
the sequence is nonincreasing, i.e.
with .
Proof 3.4.
We establish the boundedness of the iterative sequence in the following lemma.
Lemma 3.5.
Let be generated by the HALM algorithm with sufficiently small stepsize satisfying (22). Then, there exists a positive constant independent of the index such that
| (27) |
Proof 3.6.
The boundedness of is trivial since it is a unit vector. It is readily seen that the functional is coercive with respect to . It follows from 3.3 is uniformly bounded, implying that and are uniformly bounded. This proves the lemma.
Based on the above analysis, we define
In order to study the property of the limit point, we establish an upper bound for the subgradient in the following lemma.
Lemma 3.7.
There exists with
such that
| (28) | ||||
Proof 3.8.
For subproblem, from the optimality condition of the th iteration we have
| (29) |
Based on the estimate of the Lipschitz constant, we have
| (30) | ||||
Finally, under the condition in Lemma 3.3 and the estimate of the subgradient (bounded by the successive error) in Lemma 3.7, we are ready to prove the convergence of the iterative sequence generated by the HALM algorithm.
Theorem 2.
Let be a sequence generated by the HALM algorithm with adaptive stepsize satisfying (22). Then,
-
(1)
sequence has a finite length, i.e.
-
(2)
sequence converges to a critical point of .
4 Extension to general curvature-based model
In this section, we extend the HALM algorithm to a general curvature-based model [33] given in (4). Some examples of function are given as follows
Using the notations given in Section 2, one can derive a penalty model for the discrete form of (4) as follows
| (34) |
where
| (35) | ||||
Note that the HALM algorithm’s applicability extends beyond the proposed model. It can directly solve the general form in (4) given an Lipschitz smooth . Specifically, the TSC case of (4) corresponds exactly to the EE model. Moreover, for both TRV and TSC, satisfies Lipschitz smoothness and exhibits smoothness. Consequently, the associated models are amenable to direct solution via the HALM algorithm, with the generic scheme given below
where is a positive parameter.
For example, if we use the TRV model, its specific iteration scheme is as follows. For the and subproblems, one solves them exactly the same as in Algorithm 1. For the -subproblem,
where
the notation denotes the elementwise division of two vectors and , and the projection operator is defined by
for .
In the TRV model, is Lipschitz smooth with respect to variable , is convex with respect to variables and respectively, and is a Kurdyka-Łojasiewicz function. For , the above algorithm can be shown to be convergent following the proof of Theorem 2.
We remark that in the nonsmooth case using TAC, a new technique should be developed to design fast convergent algorithms, e.g. introducing more auxiliary variables to deal with the nonsmooth term. We will leave it to our future work.
5 Numerical experiments
In this section, we evaluate the performance of the HALM algorithm via a host of numerical experiments. We implement the HALM algorithm in MATLAB and conduct the numerical experiments on a desktop computer with an Intel i7-6700 CPU and 32GB RAM. First, we compare the algorithm with the DGT algorithm [7] and the HWC algorithm [11] when applied to the EE model for a Gaussian denoising problem. The effects of two algorithmic parameters are discussed as well. Then, we extend the comparison to the speckle denoising problem. Finally, we apply the algorithm to the TRV model for a Gaussian denoising problem.
For the algorithm, we have investigated two different ways to initialize : and . The latter generates better-recovered images than the former . Hence, we adopt as the default in the HALM algorithm. Unless otherwise specified, we stop the HALM algorithm when the relative error of reaches the prescribed tolerance at
| (36) |
where or the iteration number reaches .
In our experiments, the range of the grey-scale image is limited to . We use the peak signal-to-noise ratio (PSNR) and the structural similarity index measure (SSIM) to measure the quality of the restored images. The value of PSNR is defined as
where and are the recovered image and the ground-truth image, respectively. The value of SSIM is given by
where , , , , denote standard deviations, cross-covariance, and local means of images and , respectively, and are two constants [26].
5.1 Gaussian denoising by the EE model








| Image | PSNR | SSIM | ||||
| DGT | HWC | HALM | DGT | HWC | HALM | |
| #1 | 30.86 | 33.04 | 32.93 | 0.9303 | 0.9348 | 0.9317 |
| #2 | 33.06 | 35.13 | 34.63 | 0.9511 | 0.9587 | 0.9664 |
| #3 | 34.88 | 36.33 | 37.33 | 0.9518 | 0.9582 | 0.9629 |
| #4 | 31.54 | 32.38 | 34.48 | 0.8565 | 0.8613 | 0.8795 |
| #5 | 35.57 | 38.08 | 38.09 | 0.9703 | 0.9695 | 0.9697 |
| #6 | 33.16 | 33.10 | 0.9071 | 0.9048 | ||
| #7 | 31.04 | 31.31 | 0.8509 | 0.8690 | ||
| #8 | 32.47 | 32.39 | 0.9158 | 0.9019 | ||
| Image | Method | Iterations | Time (sec) | Average time per iteration |
|---|---|---|---|---|
| #1 () | DGT | |||
| HWC | ||||
| HALM | ||||
| #2 () | DGT | |||
| HWC | ||||
| HALM | ||||
| #3 () | DGT | |||
| HWC | ||||
| HALM | ||||
| #4 () | DGT | |||
| HWC | ||||
| HALM | ||||
| #5 () | DGT | |||
| HWC | ||||
| HALM | ||||
| #6 () | DGT | |||
| HWC | ||||
| HALM | ||||
| #7 () | DGT | |||
| HWC | ||||
| HALM | ||||
| #8 () | DGT | |||
| HWC | ||||
| HALM | ||||
| Average | DGT | |||
| HWC | ||||
| HALM |





In this numerical experiment, we compare the HALM algorithm with two state-of-art algorithms, the DGT and HWC algorithms, to solve the EE model. The eight ground-truth images are shown in Fig. 1. Images #1 to #5 are synthetic smoothed images, and images #6 to #8 are natural images. We add random noises following the normal distribution to these images and then employ the HALM, DGT, and HWC algorithms to denoise the degraded images. The source MATLAB codes of the DGT and HWC algorithms are kindly provided by the authors of [7] and [11], respectively. We set the same maximum number of iterations for the HALM, DGT, and HWC algorithms at . The tolerance of the relative error of given by (36) for the HALM and DGT algorithms is and that for HWC is . Note that any algorithm that runs for more than 1000 seconds in our experiment will be forced to terminate.
For a fair comparison, we adopt the suggestions for parameter setting of the DGT algorithm in [7] and the HWC algorithm in [11]. It is worth noting that both the DGT and HALM algorithms have four parameters, while the HWC algorithm has nine. We use the strategy of [7] for parameter of the DGT algorithm and set parameters at , , , and for the HWC algorithm. We choose in the HALM algorithm. For other parameters in the HALM, DGT, and HWC algorithms, we manually tune them to achieve better PSNR values.
Table 1 shows the comparison of the PSNR and SSIM values among the three algorithms. The results obtained from the HWC algorithm for images #6, #7, and #8 are missing because the algorithm has been running for over 1000 seconds and hasn’t reached the stop criterion. We observe that the HALM algorithm generates comparable high-quality restored images like the DGT and HWC algorithms. The denoised images generated by the HALM, DGT, and HWC algorithms for the #1 image are shown in Figure 2.
We record the computational costs, including the total number of iterations and the CPU times, in Table 2. The HALM algorithm is the fastest, followed by the DGT and HWC algorithms, respectively. Especially due to the lower computational cost in each iteration and the fewer iterations needed in the HALM algorithm, the average running time in this method is about of that in the DGT algorithm. The HWC algorithm is the slowest due to the cost of updating the coefficient matrices in each iteration at each pixel. The computational time of the HWC algorithm increases rapidly with the number of image pixels.
Figure 3 presents the evolution of relative errors of using the DGT, HWC, and HALM algorithms for restoring the #1 image. The relative error of the HALM algorithm decreases as the number of iterations increases, numerically validating the convergence of the algorithm, while the relative error of the DGT algorithm oscillates when its number of iterations exceeds 100. We can also see that the relative error of the HWC algorithm falls off rapidly in the initial 150 iterations, but its numerical convergence rate is lower than that of HALM.


At the end of this part, we conduct the experiment to discuss the algorithmic parameters and in the HALM algorithm. Figure 4(a) shows the PSNR values of the recovered #1 image using the HALM algorithm with . The penalty parameter in (9) should be big enough inferred from Fig. 4(a), which is consistent with the discussion at the end of section 2. We suggest use parameter in . We also test parameter and show the PSNR values of the recovered #1 image in Fig. 4(b). Basically, the parameter should be chosen small enough following the condition in Lemma 3.3. Here, we empirically choose with as the default.
5.2 Extensive tests
This subsection presents more experiments to demonstrate various aspects of the HALM algorithm. These include examining the effects of different boundary conditions and evaluating the performance of denoising binary, and real color images.




In the first experiment, we discuss the effects of different boundary conditions when using the HALM algorithm to solve the EE model. We compare the performance of the HALM algorithm under periodic and Neumann boundary conditions. For the Neumann case, we solve the -subproblem using the CG method. The denoising results for the “barbara” image are shown in Figure 5. The denoised image under the periodic boundary condition achieves a PSNR of 31.76 and an SSIM of 0.8866, while the Neumann boundary condition result has a PSNR of 31.78 and an SSIM of 0.8874. The HALM algorithm produces comparable quantitative results with both boundary conditions. However, the periodic case is faster, with a CPU time of 3.82s, versus 5.64s for the Neumann case. This is because the periodic boundary condition allows using FFT to solve the -subproblem.




In the second experiment, we apply the HALM algorithm to the EE model to denoise binary images and compare them with the DGT algorithm. We test on a “circle” image corrupted by the additive Gaussian noise following , as shown in Figure 6 (a) and (b). The denoising results by the DGT and HALM algorithms are displayed in Figure 6 (c) and (d). The denoised image by the DGT algorithm has a PSNR of 25.27 and an SSIM of 0.7358, while the HALM algorithm result achieves a PSNR of 26.07 and an SSIM of 0.8194. As the HALM algorithm is a level-set approach, it can effectively preserve the circle shape while removing noise. This demonstrates an advantage over DGT for binary image denoising.






| Method | SIDD Validation | SIDD Benchmark | ||
| PSNR | SSIM | PSNR | SSIM | |
| DGT | 33.04 | 0.8895 | 33.00 | 0.8860 |
| HALM | 33.22 | 0.8894 | 33.17 | 0.8850 |
In the third experiment, we employ the HALM algorithm to the EE model to restore real noisy images in standard RGB color spaces from the Smartphone Image Denoising Dataset (SIDD) [1]. We first denoise each color channel (R, G, B) separately and then recombine the channels to obtain the final denoised color image. Table 3 reports the denoising results in terms of average PSNR and SSIM values over the 1280 noisy image blocks from the SIDD validation data and the 1280 blocks from the SIDD benchmark data. Figure 7 (b) and Figure 7 (e) display two real noisy images from the SIDD validation data, while Figure 7 (a) and Figure 7 (d) show their corresponding ground-truth images. Figure 7 (c) presents one denoised image with a PSNR value of 26.27 and SSIM value of 0.8755. This denoised image exhibits much-improved quality compared to the original noisy image in Figure 7 (b), which has a PSNR of 19.39 and SSIM of 0.4012. The other denoised image in Figure 7 (f) with a PSNR of 36.58 and SSIM of 0.9875 also demonstrates significantly enhanced quality over the original noisy image in Figure 7 (e), which has a PSNR of 28.69 and SSIM of 0.8879. As shown in Figure 7, the HALM algorithm effectively removes noise while preserving features. However, some artificial mosaics can be observed around the edges in the restored image Figure 7 (c), likely due to the independent channel-by-channel denoising process. To address this issue, a promising approach would be denoising multiple channels concurrently. We leave the exploration of joint multi-channel denoising with EE energy as future work.
5.3 Speckle denoising




In this experiment, we apply the HALM algorithm to the EE model to denoise the corrupted optical coherence tomography (OCT) image. According to statistical optics, the noise in the OCT image is a multiplicative speckle noise. To recover a high-quality OCT image, we first perform logarithmic compression on the degraded OCT image, which makes the noise in the converted image additive. We denoise the transformed image by solving the EE model (1) with the HALM algorithm. Finally, we obtain the restored OCT image after exponential transformation.
We experiment with a synthetic OCT image generated by the Gaussian function provided in [11]. The variance of the speckle noise is 0.02. The HALM algorithm is compared with the HWC algorithm [11]. Figure 8(a) is the ground-truth OCT image, Fig. 8(b) is the noisy image, and Fig. 8(c) and (d) are denoised images by the HWC and HALM algorithm for the EE model, respectively. The HALM algorithm performs well at removing the noise and preserving features for the OCT image inferred from Figure 8. It renders better PSNR values than the HWC algorithm, since the PSNR value of the denoised image using the HALM algorithm is 27.48, and that using the HWC algorithm is 27.09.

We also test the HALM algorithm on denoising real OCT images from the large dataset of labeled OCT and chest X-ray images [12]. Two representative OCT images are selected from the dataset. The results are shown in Figure 9. The noisy images are displayed in the first row, and the corresponding denoised results using the HALM algorithm are shown in the second row. As illustrated in Figure 9, the HALM algorithm effectively reduces noise in the regions of interest while preserving important features and anatomical structures in the real OCT images.
5.4 Gaussian denoising by the TRV model




In this experiment, we use the HALM algorithm described in Section 4 to solve the TRV model, which is called the HALM-TRV algorithm, and compare it with the discrete total curvature (DTC) algorithm proposed in [33]. The DTC method transfers the TRV model to a re-weighted total variation minimization problem and solves it by the alternating direction method of multipliers (ADMM) based algorithm. The source MATLAB code of the DTC method is kindly provided by the authors of [33]. We experiment with the “shading” image and degrade it with the additive Gaussian noise with a mean of 0 and a variance of 0.0015 (see Fig. 10 (a) and (b)). We set and in the TRV model. For the HALM-TRV algorithm, we choose and . For the DTC algorithm, the parameters are recommended by the authors of [33]. Figure 10 (c) and (d) show the denoised images by the HALM-TRV and DTC algorithms, respectively. The DTC algorithm generates a restored image with a PSNR value of 32.08 and an SSIM value of 0.9356, and the HALM-TRV algorithm produces a denoised image with a PSNR value of 33.67 and an SSIM value of 0.9410. We also record the CPU running time of the two algorithms. The CPU time of the DTC algorithm is 1.2900 seconds, and that of the HALM-TRV algorithm is 0.2764 seconds. We notice that the proposed HALM-TRV algorithm outperforms the DTC algorithm in the quality of the denoised image and the computational cost for solving the TRV model.
6 Conclusions
We have proposed a novel bilinear decomposition for the EE model and developed a fast HALM algorithm for its discrete form. We rigorously prove the convergence of the generated minimizing sequence from the algorithm and then validate it numerically. A host of numerical experiments are conducted to demonstrate the performance of the new HALM algorithm in its computation cost and the quality of the recovered images. The proposed algorithm has a great potential for general curvature-based models.
In reference to the latest operator-splitting algorithm presented in [13], we need to point out that the reformulation strategy and the solution method for each subproblem devised for the HALM algorithm are quite different from the strategy developed in [13]. It seems the HALM algorithm cannot be used directly for the Gaussian curvature model to gain its computational efficiency since it will not lead to easy-to-solve sub-minimization problems and thereby lose its computational advantage. Nontrivial splitting technique should be developed. The convergence of the HALM algorithm for the more general models has not yet been established when the smoothness of the objective function is lacking (e.g. TAC model and the Gaussian curvature regularization model [13]). They will be a part of our future work.
Acknowledgments
We would like to thank Drs. Liangjian Deng, Fang He and Qiuxiang Zhong for providing the source codes of the DGT, HWC, and DTC methods, respectively, and for their fruitful discussions about the experiments.
References
- [1] A. Abdelhamed, S. Lin, and M. S. Brown, A high-quality denoising dataset for smartphone cameras, in 2018 IEEE/CVF Conference on Computer Vision and Pattern Recognition (CVPR), 2018, pp. 1692–1700, https://doi.org/10.1109/CVPR.2018.00182.
- [2] H. Attouch, J. Bolte, P. Redont, and A. Soubeyran, Proximal alternating minimization and projection methods for nonconvex problems: An approach based on the Kurdyka-Łojasiewicz inequality, Mathematics of Operations Research, 35 (2010), pp. 438–457, https://doi.org/10.1287/moor.1100.0449.
- [3] J. Bolte, S. Sabach, and M. Teboulle, Proximal alternating linearized minimization for nonconvex and nonsmooth problems, Mathematical Programming, 146 (2013), https://doi.org/10.1007/s10107-013-0701-9.
- [4] K. Bredies, T. Pock, and B. Wirth, A convex, lower semicontinuous approximation of Euler’s elastica energy, SIAM Journal on Mathematical Analysis, 47 (2015), pp. 566–613, https://doi.org/10.1137/130939493.
- [5] A. Chambolle and T. Pock, Total roto-translational variation, Numerische Mathematik, 142 (2019), pp. 611–666, https://doi.org/10.1007/s00211-019-01026-w.
- [6] T. F. Chan, S. H. Kang, and J. Shen, Euler’s elastica and curvature-based inpainting, SIAM Journal on Applied Mathematics, 63 (2002), pp. 564–592, https://doi.org/10.1137/S0036139901390088.
- [7] L.-J. Deng, R. Glowinski, and X.-C. Tai, A new operator splitting method for the Euler elastica model for image smoothing, SIAM Journal on Imaging Sciences, 12 (2019), pp. 1190–1230, https://doi.org/10.1137/18M1226361.
- [8] Y. Duan, Y. Wang, X.-C. Tai, and J. Hahn, A fast augmented Lagrangian method for Euler’s ealstica model, Numerical Mathematics: Theory, Methods and Applications, 6 (2012), pp. 47–71, https://doi.org/10.4208/nmtma.2013.mssvm03.
- [9] R. Glowinski and P. Le Tallec, Augmented Lagrangian and operator-splitting methods in nonlinear mechanics, SIAM, 1989.
- [10] R. Glowinski, S. Osher, and W. Yin, eds., Splitting Methods in Communication, Imaging, Science, and Engineering, Springer-Verlag New York, 2016.
- [11] F. He, X. Wang, and X. Chen, A penalty relaxation method for image processing using Euler’s elastica model, SIAM Journal on Imaging Sciences, 14 (2021), pp. 389–417, https://doi.org/10.1137/20M1335601.
- [12] D. S. Kermany, M. Goldbaum, W. Cai, et al., Identifying medical diagnoses and treatable diseases by image-based deep learning, Cell, 172 (2018), pp. 1122–1131.e9, https://doi.org/https://doi.org/10.1016/j.cell.2018.02.010.
- [13] H. Liu, X.-C. Tai, and R. Glowinski, An operator-splitting method for the Gaussian curvature regularization model with applications to surface smoothing and imaging, SIAM Journal on Scientific Computing, 44 (2022), pp. A935–A963, https://doi.org/10.1137/21M143772X.
- [14] H. Liu, X.-C. Tai, R. Kimmel, and R. Glowinski, A color elastica model for vector-valued image regularization, SIAM Journal on Imaging Sciences, 14 (2021), p. 717–748, https://doi.org/10.1137/20M1354532.
- [15] Z. Liu, Y. Duan, C. Wu, and X.-C. Tai, On variable splitting and augmented lagrangian method for total variation-related image restoration models, in Handbook of Mathematical Models and Algorithms in Computer Vision and Imaging, K. Chen, C.-B. Schönlieb, X.-C. Tai, and L. Younces, eds., Springer International Publishing, Cham, 2021, pp. 1–47, https://doi.org/10.1007/978-3-030-03009-4_84-2.
- [16] Z. Liu, S. Wali, Y. Duan, H. Chang, C. Wu, and X.-C. Tai, Proximal ADMM for Euler’s elastica based image decomposition model, Numerical Mathematics: Theory, Methods and Applications, 12 (2019), pp. 370–402, https://doi.org/10.4208/nmtma.OA-2017-0149.
- [17] S. Masnou and J.-M. Morel, Level lines based disocclusion, in Proceedings 1998 International Conference on Image Processing. ICIP98 (Cat. No.98CB36269), IEEE Comput. Soc, 1998, https://doi.org/10.1109/icip.1998.999016.
- [18] D. Mumford, Elastica and computer vision, in Algebraic geometry and its applications, Springer, 1994, pp. 491–506.
- [19] Y. E. Nesterov, A method for solving the convex programming problem with convergence rate (in russian), in Dokl. Akad. Nauk SSSR, vol. 269, 1983, pp. 543–547.
- [20] J. Nocedal and S. J. Wright, Numerical Optimization, Springer New York, NY, 2nd ed., 2006.
- [21] A. L. Peressini, F. E. Sullivan, and J. J. Uhl, The Mathematics of Nonlinear Programming, Springer-Verlag New York, 1988.
- [22] T. Ringhølm, J. Lazić, and C. Schönlieb, Variational image regularization with Euler’s elastica using a discrete gradient scheme, SIAM Journal on Imaging Sciences, 11 (2018), pp. 2665–2691, https://doi.org/10.1137/17M1162354.
- [23] X.-C. Tai, J. Hahn, and G. J. Chung, A fast algorithm for Euler’s elastica model using augmented Lagrangian method, SIAM Journal on Imaging Sciences, 4 (2011), p. 313–344, https://doi.org/10.1137/100803730.
- [24] C. R. Vogel, Computational methods for inverse problems, SIAM, 2002.
- [25] C. Wang, Z. Zhang, Z. Guo, T. Zeng, and Y. Duan, Efficient SAV algorithms for curvature minimization problems, IEEE Transactions on Circuits and Systems for Video Technology, (2022), https://doi.org/10.1109/TCSVT.2022.3217586.
- [26] Z. Wang, A. Bovik, H. Sheikh, and E. Simoncelli, Image quality assessment: From error visibility to structural similarity, IEEE Transactions on Image Processing, 13 (2004), pp. 600–612, https://doi.org/10.1109/TIP.2003.819861.
- [27] C. Wu and X.-C. Tai, Augmented Lagrangian method, dual methods, and split Bregman iteration for ROF, vectorial TV, and high order models, SIAM Journal on Imaging Sciences, 3 (2010), pp. 300–339, https://doi.org/10.1137/090767558.
- [28] M. Yashtini and S. H. Kang, A fast relaxed normal two split method and an effective weighted TV approach for Euler’s elastica image inpainting, SIAM Journal on Imaging Sciences, 9 (2016), pp. 1552–1581, https://doi.org/10.1137/16M1063757.
- [29] J. Zhang and K. Chen, A new augmented Lagrangian primal dual algorithm for elastica regularization, Journal of Algorithms & Computational Technology, 10 (2016), pp. 325–338, https://doi.org/10.1177/1748301816668044.
- [30] J. Zhang, R. Chen, C. Deng, and S. Wang, Fast linearized augmented Lagrangian method for Euler’s elastica model, Numerical Mathematics: Theory, Methods and Applications, 10 (2017), pp. 98–115, https://doi.org/10.4208/nmtma.2017.m1611.
- [31] J. Zhang, Y. Duan, Y. Lu, M. K. Ng, and H. Chang, Bilinear constraint based ADMM for mixed Poisson-Gaussian noise removal, Inverse Problems & Imaging, 15 (2021), pp. 339–366, https://doi.org/10.3934/ipi.2020071.
- [32] Y. Zhang, S. Li, Z. Guo, B. Wu, and S. Du, Image multiplicative denoising using adaptive Euler’s elastica as the regularization, Journal of Scientific Computing, 90 (2022), p. 69, https://doi.org/10.1007/s10915-021-01721-7.
- [33] Q. Zhong, Y. Li, Y. Yang, and Y. Duan, Minimizing discrete total curvature for image processing, in 2020 IEEE/CVF Conference on Computer Vision and Pattern Recognition (CVPR), 2020, pp. 9471–9479, https://doi.org/10.1109/CVPR42600.2020.00949.
- [34] W. Zhu, X. C. Tai, and T. Chan, Image segmentation using Euler’s elastica as the regularization, Journal of Scientific Computing, 57 (2013), pp. 414–438, https://doi.org/10.1007/s10915-013-9710-3.